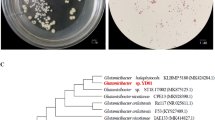

Abstract
Background and aims
Soil salinity stress affects the health and growth of crops. The use of plant growth-promoting rhizobacteria (PGPR) to improve the salt tolerance of plants is gaining acceptance worldwide. Here, a halotolerant, plant growth-promoting actinobacterium Glutamicibacter halophytocola KLBMP 5180, recently isolated from the root of a coastal halophyte Limonium sinense, was investigated for its capacity on the growth of tomato seedlings under the condition of saline stress.
Methods
Tomato seedlings were inoculated with strain KLBMP 5180 and irrigated with 2% NaCl salt-stress treatment. Plant growth and physiological responses were determined after harvest. The genome of strain KLBMP 5180 was sequenced and analyzed.
Results
High salinity significantly reduced the growth and biomass of tomato seedlings. However, KLBMP 5180 inoculation significantly improved tomato growth in terms of seedling fresh weight and height, root length and fresh weight, and number of fibrous roots, along with increased osmolyte content (proline) and antioxidant defense enzymes and regulation of ion homeostasis under salt stress. From the genome, we identified a series of genes that may contribute to plant growth promotion, including genes for nitrogen fixation, biosynthesis of siderophores and exopolysaccharides. Additionally, several genes related to high salinity tolerance, such as Na+/H+ antiporter, K+ transporter, glycine-betaine synthesis and transport, and several heavy metal resistance and biodegradation genes were also identified in the genome of strain KLBMP 5180.
Conclusion
Our results demonstrate that the halotolerant strain KLBMP 5180 can be used to improve tomato seedling growth in saline soil and act as a potential agricultural biofertilizer agent in future applications.
Similar content being viewed by others
Avoid common mistakes on your manuscript.
Introduction
Soil salinity is one of the serious abiotic stresses affecting crop performance, as it inhibits seed germination and seedling growth and leads to yield reduction (Cuartero et al. 2006). Worldwide, large areas of soil have been salinized. It is estimated that more than 50% of the agricultural land will be salinized by 2050 (Jamil et al. 2011). High salinity in soil decreases the ability of plants to absorb water and nutrients, and destroys the balance of ions and osmosis in cells (Shilpi and Narendra 2005). Plants have evolved complex physiological, biochemical, and molecular level strategies to respond to salt stress, including accumulation of osmotic regulators (e.g., proline, trehalose, and glycine-betaine), and production of protective antioxidant enzymes and secondary metabolites (e.g., peroxidases, catalases, superoxide dismutase, and flavonoids) to scavenge reactive oxygen species (ROS). In addition, plants can resist salt stress by controlling the Na+ homeostasis and ionic balance, and regulating signal transduction pathways related to plant phytohormones, such as abscisic acid (ABA), salicylic acid (SA), and jasmonic acids (JA) (Mickelbart et al. 2015; Caarls et al. 2015). Therefore, it is very urgent and important to take effective approaches to improve the salt tolerance of crops.
Some traditional strategies, e.g., modern genetic engineering and genome editing techniques have been used to improve salt stress in crops (Wei et al. 2017; Li et al. 2018). At present, genetically modified crops are not yet widely accepted. Therefore, using an environment-friendly approach to improve the salinity tolerance of crops and remediate saline soils is still challenging (El-Esawi et al. 2018). The use of beneficial plant rhizospheric microorganisms and endophytes has shown a great potential in enhancing plant growth and health under both normal and various stress conditions without harming the environment (Wani et al. 2015; Berg et al. 2016; Qin et al. 2017; Zhang et al. 2019). Beneficial endophytes have been successfully used in improving crop and plant growth as well as amelioration of stress-induced damage, such as salinity (Qin et al. 2014; Barnawal et al. 2017), drought (Sheibani-Tezerji et al. 2015), and heavy metal (Płociniczak et al. 2018). They are known to improve plant growth and stress tolerance via a range of direct and indirect mechanisms, including fixing nitrogen, producing phytohormones including indole acetic acid (IAA), solubilizing phosphate and potassium, synthesizing 1-aminocyclopropane-1-carboxylic acid (ACC) deaminase, siderophores, extracellular hydrolytic enzymes, and antibiotics (Qin et al. 2011; Glick 2014; Ma et al. 2016).
Tomato is an important and nutritious vegetable crop, which is popular all over the world. However, due to salinization of soil and irrigation water, tomato production has been greatly restricted, leading to yield reduction (Turhan and Seniz 2012). Several studies have used plant growth promotion bacteria to alleviate salt stress and promote tomato growth (Kim et al. 2014; Palaniyandi et al. 2014; Win et al. 2018). However, there were few reports on the use of natural salt-tolerant PGPR strains. Previously, we obtained several halotolerant plant growth promotion (PGP) endophytic and rhizospheric bacteria from coastal halophytes. Inoculation of Limonium sinense and wheat seedlings under greenhouse conditions showed significant PGP effect under salt stress (Qin et al. 2014; Wang et al. 2017; Gong et al. 2018). Moreover, a new endophytic actinobacterium, Glutamicibacter halophytocola KLBMP 5180 (Feng et al. 2017), isolated from the root tissues of the halophyte Limonium sinense, significantly promoted host growth under NaCl stress via complex physiological and molecular mechanisms (Qin et al. 2018). Thus, our results revealed that this natural halotolerant strain is a promising candidate for plant growth promotion agent, which could be used for the crop growth under salt stress conditions. However, its mechanisms of salt tolerance and PGP properties remain unknown.
Therefore, the aims of the present study were (1) to evaluate the plant growth promotion effect with and without inoculation of strain KLBMP 5180 in tomato seedlings under the stress condition of 2% NaCl in greenhouse, (2) to investigate the effects on the physiological changes (osmolyte, antioxidant defense enzymes, and ion contents) of tomato seedlings (leaves and stems) after KLBMP inoculation in greenhouse under salt stress, and (3) to explore the plant growth promotion and salt-tolerant mechanisms of strain KLBMP 5180 by genome sequencing, annotation and analysis.
Materials and methods
Strain type and the culture condition
The halotolerant PGP strain, G. halophytocola KLBMP 5180, was previously isolated from the coastal halophyte Limonium sinense (Feng et al. 2017) and was obtained from the Key Laboratory of Biotechnology for Medicinal Plants of Jiangsu Province (Xuzhou, China). The strain was cultured in a 250 mL Erlenmeyer flask containing 100 mL yeast extract-malt extract medium broth (ISP 2, International Streptomyces Project; Shirling and Gottlieb 1966) at 150 rpm and 28 °C for 5 days.
Construction of rifampicin-resistant G. halophytocola KLBMP 5180
The rifampicin-resistant derivatives of strain G. halophytocola KLBMP 5180rif were developed by inoculation in ISP 2 broth containing 50 μg mL−1 rifampicin. Then, the culture was spread on ISP 2 agar plates containing 50 μg mL−1 rifampicin and was incubated at 28 °C for 36 h. The colonies obtained were further inoculated in ISP 2 broth containing 100 μg mL−1 rifampicin, and colonies were further selected on higher concentration rifampicin at an interval of 50 μg mL−1. After repeats of “inoculation broth-spreading agar,” the 300 μg mL−1 rifampicin-resistant strain KLBMP 5180rif was obtained.
Strain inoculation and tomato seedlings salt stress
Seeds of the tomato (Jingpeng No.1) purchased from Shouguang Jinkai Seed Industry Co., Ltd. (Shouguang, China), were surface sterilized with 75% ethanol for 3 min, followed by rinsing three times with sterile water. After that, seeds were sown in plastic pots containing sterilized soil for germination and seedling growth in an illumination incubator (25 °C, 14/10 h light/dark, relative humidity 60%) for 5 days. Then, tomato seedlings with identical growth size were selected and transferred into plastic cups (bottom diameter: 4 cm, depth: 7.6 cm) containing sterile soil (70 g) for further cultivation for 3 days under the same greenhouse conditions. For tomato seedling inoculation, the PGP strain cells (cultured in ISP 2 broth as described above) were harvested by centrifugation (4500 rpm, 10 min), washed once with sterile distilled water and then re-suspended in sterile distilled water to the final concentration (OD600 = 0.8). Then, seedlings were inoculated with 35 mL of KLBMP 5180rif suspensions (five inoculations, once every two days) or with sterile water as the control (ten biological replicates for each inoculated and non-inoculated). Five days after inoculation, seedlings were root-irrigated with 35 mL of 200 mM NaCl every two days (a total of five irrigations) to a final 2% NaCl in the soil. After seven days of salt stress, seedling fresh weights and heights, root fresh weights and length, and number of fibrous roots were measured.
Strain rhizosphere colonization
Root colonization and survival rate of inoculated KLBMP 5180rif were checked by a dilution plating technique. Determination of the number of colonies forming units (CFU) was performed on ISP 2 agar plates containing 200 μg mL−1 rifampicin using rhizosphere soils of inoculated tomato seedlings at 2, 7, and 13 days after salt stress.
Plant physiological measurements
To measure the plant growth and physiological traits, five seedlings from each replicate were randomly selected. The total chlorophyll estimation of the leaves for different treatments was done according to the method of Ali et al. (2014). The proline content of leaves and stems was determined by spectrophotometric analysis at 520 nm using a kit (A107, Nanjing Jiancheng Bioengineering Institute, Nanjing, China). Malondialdehyde (MDA) concentration was measured according to the thiobarbituric reaction (Heath and Packer 1968). Total soluble sugar of the leaves and stems was estimated by the phenol-sulfuric acid method (Dubois et al. 1956). For antioxidant enzyme extraction, fresh plant tissues (0.5 g) were homogenized and extracted in 5–10 mL of ice-cold 50 mM phosphate buffer (pH 7.0) supplemented with 1% polyvinylpyrrolidone and 0.1 mM EDTA. The crude extract was centrifuged at 10,000×g for 20 min at 4 °C, and the obtained supernatant was used for the antioxidant assay. Peroxidases (POD), catalases (CAT), and superoxide dismutase (SOD) were measured as described by previous methods (Beauchamp and Fridovich 1971; Kar and Mishra 1976; Singh and Jha 2017). For leaf and stem ion content, tissues were first oven-dried and HNO3-treated according to the method of Zhang et al. (2014). The Na+, K+, and Ca2+ contents of leaves and roots were analyzed according to detection kits (C002 for Na+, C001–2 for K+, and C004–1 for Ca2+, Nanjing Jiancheng Bioengineering Institute, China) according to the manufacturer’s instructions.
Genomic sequencing, assembly, and analysis
Genomic DNA of strain KLBMP 5180 was extracted according to the previous method (Qin et al. 2015). Then, the genome was sequenced by integrating the Illumina Miseq and Pacific Bioscience (PacBio) RS II sequencing platform at Majorbio Biotech Co., Ltd. (Shanghai, China) according to standard protocols. The reads were assembled by software SOAPdenovo v2.04 (Li et al. 2010) and Celera Assembler v8.0 (Myers et al. 2000) after the quality control. SOAP GapCloser V1.12 was used to close gaps after assembly. The protein coding sequences (CDS) were predicted by Glimmer 3.02 (Delcher et al. 2007) and Prokaryotic Genome Annotation Pipeline (PGAP) on NCBI (Pruitt et al. 2012). The function annotation of the genome sequence was based on a BLAST search against the different function databases: GO (http://www.geneontology.org/), COG (http://www.ncbi.nlm.nih.gov/COG/), and KEGG (http://www.genome.jp/kegg/). A circular genome map with functional annotation was plotted using Circos software (Krzywinski et al. 2009). The secondary metabolite biosynthesis was predicted according to antiSMASH 4.0 (Blin et al. 2017). The genome sequences have been deposited at GenBank under the accession numbers CP012750 for chromosome and CP012751 for plasmid.
Data analysis
Data were analyzed using the GraphPad Prism 5.0 software. Results are expressed as mean values ± standard deviation (SD) for three independent replicates. The statistical significance between treatments was assessed by one-way analysis of variance. P < 0.05 was considered statistically significant.
Results
Effect of strain inoculation improves tomato growth under NaCl stress
After 7 days of the NaCl treatment, the plant growth and physiological parameters were statistically analyzed. Results showed that inoculation of strain KLBMP 5180 significantly promoted tomato seedling growth under both non-saline and salt stress conditions (Fig. 1a and b). Plant growth was significantly inhibited when exposed to a high concentration of NaCl. However, KLBMP 5180-inoculated seedlings had significantly higher biomass (seedlings and root fresh weight and number of fibrous roots) and heights than the control (Fig. 2a–e). Fresh root weights were found to have increased by 28.6% and 26.5% with and without NaCl stress, respectively (Fig. 2e). The total chlorophyll content of leaves treated with 200 mM NaCl was not affected (Fig. 2f).
Effect of G. halophytocola KLBMP 5180 strain inoculation on the growth of tomato seedlings with and without the NaCl stress condition, and its rhizosphere colonization density. a, aerial part; b, whole seedlings differences in control and strain KLBMP 5180 inoculation (P0 and P200 represent 0 and 200 mM NaCl stress, and P0 + 5180 and P200 + 5180 represent strain KLBMP 5180 inoculation under 0 and 200 mM NaCl stress, respectively); and c, rhizosphere colonization density of strain KLBMP 5180 under 0 and 200 mM NaCl stress conditions. The asterisk (*) indicates P < 0.05 (t test) for treatment versus control
Effect of G. halophytocola KLBMP 5180 strain inoculation on the growth of tomato seedlings with and without the NaCl stress condition. a number of fibrous roots; b root length; c plant height; d plant fresh weight; e root fresh weight; and f total chlorophyll content. Values are means, and bars indicate SDs. The asterisk (*) indicates P < 0.05 (t test) for treatment versus control
Effect of strain inoculation on tomato antioxidants, proline, and soluble sugars
Strain KLBMP 5180 did not improve the soluble sugar content of the leaves and stems with or without NaCl stress. Inoculation with KLBMP 5180 significantly increased the proline content in the leaves and stems under both non-saline and salt stress conditions. Proline content in leaves and stems was increased by 110% and 86.7% (P < 0.05), respectively, under 0 mM NaCl, whereas it was increased by 40.4% and 39.2% (P < 0.05), respectively, under the 200 mM NaCl stress treatment. With KLBMP 5180 inoculation, the MDA content was decreased by 15.8% in stems compared with that of the control under NaCl stress conditions (Table 1).
Under salt stress, KLBMP 5180 significantly increased the accumulation of antioxidant enzymes. KLBMP 5180 inoculation increased the stem SOD activity by 57.1% and 37%, respectively, and slightly increased leaf SOD activity by 7.6% and 9.4%, respectively, under both non-saline and salt stress conditions (Fig. 3a). Considering the POD activity, higher activity of 35.2% and 160.8% was observed significantly in leaves and stems, respectively, under NaCl stress treatments, compared to the control seedlings (Fig. 3c). Strain KLBMP 5180 significantly increased the stem CAT accumulation 4.8-fold and 5.3-fold, compared to non-inoculated plants, with 200 mM NaCl and without NaCl treatments, respectively. In leaves, CAT activity was also increased 1.47-fold and 0.4-fold under both non-saline and salt stress conditions (Fig. 3b). Overall, the results indicated that inoculation with KLBMP 5180 increased host proline and antioxidants as well as reduced lipid peroxidation, therefore protecting tomato seedlings from salt stress.
Effect of G. halophytocola KLBMP 5180 strain inoculation on the seedling antioxidant defense enzymes content with and without the NaCl stress condition. a, SOD; b, CAT; and c, POD. One asterisk (*) and two asterisks (**) indicate P < 0.05 and P < 0.01 (t test), respectively, for treatment versus control
Effect of strain inoculation on tomato ion accumulation
The seedling ion profile was significantly altered in response to strain KLBMP 5180 inoculation. Na+ content in plant stems and leaves increased significantly after salt stress. With KLBMP 5180 inoculation, the content of Na+ in leaves and stems was decreased by 96.5% and 23.5%, respectively, compared to the un-inoculated seedlings (Fig. 4a). There was no significant difference for K+ concentration in leaves under both non-saline and salt stress conditions. However, K+ content in the stems of inoculated seedlings was significantly higher under both 0 and 200 mM NaCl stress, compared to the un-inoculated plants (Fig. 4b). The K+/Na+ ratio was also calculated from the Na+ and K+ concentrations. NaCl stress decreased the K+/Na+ ratio in leaves and stems, strain KLBMP 5180 inoculation increased the stem K+/Na+ ratio by 102.5% and 170.5% and the leaf K+/Na+ ratio by 10.2% and 33.3% under 0 and high NaCl stress treatments, respectively (Fig. 4d). At the same time, the content of Ca2+ was increased under salt or salt-free conditions. Ca2+ content in tomato stems was increased by 4.1-fold and 0.3-fold, whereas in leaves, it was increased by 3.2-fold and 0.3-fold, under salt-free and salt stress conditions, respectively (Fig. 4c), when compared to un-inoculated seedlings.
Effect of G. halophytocola KLBMP 5180 strain inoculation on tomato seedling Na+, K+, and Ca2+ content and K+/ Na+ ratio with and without the NaCl stress condition. a, Na+ content; b, K+ content; c, Ca2+ content; and d, K+/ Na+ ratio. Values are means, and bars indicate SEs. One asterisk (*) and two asterisks (**) indicate P < 0.05 and P < 0.01 (t test), respectively, for treatment versus control
Colonization of tomato by G. halophytocola KLBMP 5180
Strain KLBMP 5180 was found only colonizing the rhizosphere soil, and not in the endosphere of tomato seedlings. Colonization efficiency of strain KLBMP 5180 in the rhizosphere soil of tomato seedlings was measured by plate counting method. Obviously, the rhizosphere colonization density of strain KLBMP 5180rif was higher under salt-free than salt stress condition. After different days of salt stress, KLBMP 5180rif population density (log CFU g−1) decreased from 6.27 to 5.11 in the rhizosphere soil, whereas without salt stress, its density decreased from 6.46 to 5.53 (Fig. 1c). No bacterial colonies were observed on rifampicin-nutrient agar plates from un-inoculated control seedlings rhizospheric soil.
Genome characteristics of strain G. halophytocola KLBMP 5180
The complete genome of strain G. halophytocola KLBMP 5180 consists of a 3,911,798-bp circular chromosome and one 6626-bp circular plasmid (Fig. 5a and b). The G + C content of the chromosome and the plasmid was 60% and 53.7%, respectively. The chromosome contains 3624 CDSs, 19 rRNA, and 65 tRNA genes, whereas the plasmid contains 8 CDSs (Table 2). Five secondary metabolism-related gene clusters related to siderophore, non-ribosomal peptide synthetase (NRPS), betalactone, and terpene biosynthesis were detected in the genome (Table 3). The similarity of these gene clusters is relatively low, ranging from 6 to 75%, suggesting that strain KLBMP 5180 has the potential to produce new secondary metabolites.
Genes related to PGP and salt environment adaption
Among these CDSs, 1503 genes were classified into 21 COG functional categories. Most of the genes were associated with functions such as amino acid transport and metabolism, carbohydrate transport and metabolism, translation, ribosomal structure and biogenesis, cell cycle control, cell division, chromosome partitioning, and inorganic ion transport and metabolism (Fig. 6a). The cellular component, molecular function and biological process of the genome information were also classified via the GO database (Fig. 6b). From the genome, many genes located in the chromosome were detected to be involved in plant growth promotion, including nitrogen fixation (nifU), IAA secretion (iaaM), siderophore (sbnA), spermidine (speB), and phenazine (phzCEF) biosynthesis (Table 4). In addition, genome analysis revealed the presence of entire genes responsible for the biosynthesis of exopolysaccharide (EPS), which could protect bacterial cells against oxidative stress and enhance plant growth under stress conditions (Meneses et al. 2017). These genes are involved in four distinct steps for the biosynthesis of EPS, including biosynthesis of nucleoside diphosphate sugars (NDP-sugars), assembly on lipid-acceptor, modification, and transport of EPS (Table 5). Furthermore, G. halophytocola KLBMP 5180 contains many genes related to salt tolerance. For example, genes encoding Na+/H+ antiporter and K+ transporter can be activated under salt stress and thus avert the ingress of Na+. The key genes (betABP) for glycine-betaine synthesis and transport were found in the genome, which are considered as effective genes responsible for salt tolerance (Liu et al. 2016). In addition, the genome has a set of heavy metal resistance genes that are resistant to arsenic, copper, tellurium, and cobalt-zinc-cadmium. We also found that this genome has various biodegradation genes that are involved in phenylacetic acid, phenol, 4-hydroxybenzoate, and chitin degradation (Table 4).
Discussion
Salt stress is one of the main abiotic stress factors limiting crop yield worldwide (Rozema and Flowers 2008). Tomato is a favorite crop all over the world, but its growth is sensitive to salt stress. At present, using PGPR to alleviate the damage to plants caused by abiotic stress is gaining increased interest and has been considered as a promising alternative for agricultural growth. Several studies have already been conducted on PGP microorganisms and their effects on tomato plant growth under the condition of salt stress (Palaniyandi et al. 2014; Fan et al. 2016; Damodharan et al. 2018; Van Oosten et al. 2018). These strains are mainly from the genera Streptomyces, Bacillus, Pseudomonas, Azotobacter, and Arthrobacter and showed vital PGP traits, including IAA production, nitrogen fixation, and siderophore and ACC deaminase biosynthesis. The salt-tolerant actinomycete, G. halophytocola KLBMP 5180, which was previously found to have multiple PGP traits and tolerate 10% NaCl, significantly promoted the growth of halophyte Limonium sinense (Qin et al. 2018), meriting further exploration of its potential for PGP effects for crops under saline soil conditions. Our current study showed that this strain significantly promoted the growth of tomato seedlings under high salt stress and can colonize successfully the rhizosphere soil of non-host plant tomatoes with or without salt stress (Fig. 1), although the direct evidence still needs to be confirmed by scanning electron microscopy or the GFP-marked method.
The strain KLBMP 5180 is a new member of the genus Glutamicibacter (Feng et al. 2017), which was recently reclassified from the genus Arthrobacter (Busse 2016). Members of the genus Arthrobacter are widely distributed in different ecological environments and display many ecological functions, such as plant growth promotion, biodegradation, and bioremediation (Cycoń et al. 2017; Viegas et al. 2019). Previous studies have also found that strains of Arthrobacter spp. could promote plant growth under salt stress condition (Fan et al. 2016; Van Oosten et al. 2018). However, there are only a few reports on the study of the natural halotolerant endophyte-origin Arthrobacter spp. and their PGP effect under salt stress. Recent studies have shown that salt-tolerant PGPR strains are involved in conferring salinity tolerance in various crops (Sharma et al. 2016; Banik et al. 2018). Therefore, our experiments have proven the advantages and application potential of the halotolerant PGP bacteria in improving plant salt tolerance.
Proline acts as an osmoprotectant, which protects the plant cells from oxidative damage. The present study revealed that KLBMP 5180 inoculation enhanced the proline content of the leaves and stems. Reactive oxygen species (ROS) accumulation in NaCl-stressed plant cells leads to lipid peroxidation, which is estimated via the accumulation of MDA. Moreover, MDA content in stems was also decreased after KLBMP 5180 treatment, suggesting its ability to prevent soil NaCl-induced lipid peroxidation of cell membranes. Our results are in good agreement with previous studies (Akram et al. 2016; Pereira et al. 2016) in which maize and sunflower plants treated with PGPR show less accumulation of MDA and increased proline content under saline conditions. In this study, strain KLBMP 5180 inoculation significantly improved the POD, SOD, and CAT content in tomato seedlings under salinity stress (Fig. 3), which may thereby lead to low-level accumulation of ROS. This is in accordance with recent results in both Enterobacter sp. and Streptomyces KLBMP 5084 in which PGPR-inoculated plants exhibited higher antioxidant enzyme content (Qin et al. 2017; Sarkar et al. 2018). These results imply that G. halophytocola KLBMP 5180 could protect tomato seedlings and withstand salinity stress by regulating both osmoprotectants and ROS-scavenging enzyme accumulation.
Among the mechanisms used by PGPR, regulating ion balance and maintaining a high K+/Na+ ratio is considered as an important mechanism for eliminating salt stress toxicity and promoting plant growth (Munns and Tester 2008). In this study, the Na+ concentration of both leaves and stems of tomato seedlings increased with the rise in NaCl concentration. However, strain KLBMP-inoculated seedlings showed lower Na+ concentration, increased K+ uptake, and higher K+/Na+ ratio in both leaves and stems than non-inoculated seedlings under NaCl stress (Fig. 4). Our results are in accordance with recent studies that have reported that PGPR can promote various crops and plants growth and maintain lower Na+ and Na+/K+ ratio to withstand salt toxicity (Ramadoss et al. 2013; Niu et al. 2016; Chen et al. 2016; Sharma et al. 2016). We also observed an increased Ca2+ accumulation after KLBMP 5180 inoculation as compared to the non-inoculated control under both the 0 and 200 mM NaCl treatments. As a secondary messenger signaling molecule, Ca2+ plays an important regulatory role in plant salt stress response. Maintenance of high Ca2+ accumulation can improve plant resistance to salt stress (Yang et al. 2016). The present study indicated that the PGP strain KLBMP 5180 might regulate tomato seedlings to selectively take up and transport Ca2+ to maintain a high Ca2+/Na+ ratio. However, detailed physiological and molecular mechanisms of salt tolerance mediated by this strain need to be further explored.
The developments of -omics techniques enable us to better understand the plant growth promotion and the environmental adaptation mechanisms of PGPR at the molecular level (Qin et al. 2016). Genome sequencing and analysis revealed that strain KLBMP 5180 harbors a series of genes related to plant growth promotion and salt stress tolerance. A single nitrogen fixation-related gene (nifU) was detected in the genome. However, there is no complete nitrogen fixation gene cluster in the KLBMP 5180 genome. The real nitrogen fixation capacity of this strain still needs to be confirmed by acetylene reduction tests. Strain KLBMP 5180 genome contains IAA, siderophores, and spermidine biosynthesis genes (Table 4). These genes have been demonstrated to be involved in the PGP effects of PGPR (Afzal et al. 2014; Wang et al. 2017). Recent studies have shown that the endophyte Klebsiella sp. LTGPAF-6F and the rhizobacterium Bacillus amyloliquefaciens SQR9 have the spermidine synthesis genes and induced growth, drought, and salt tolerance in wheat and Arabidopsis seedlings (Zhang et al. 2017; Chen et al. 2017). Therefore, whether strain KLBMP 5180 can improve the salt tolerance of tomato seedlings by secreting spermidine needs further detection. It is noteworthy to mention that in this strain, we have found complete gene clusters of EPS biosynthesis, including genes for NDP-sugars synthesis, assembly, modification, and transportation of the entire EPS synthesis process (Table 5). It has been demonstrated that bacterial EPS can help bacteria to resist abiotic stresses, absorb sodium ions, resist ROS stress, promote plant growth, resist salt and drought stress (Liu et al. 2017; Lu et al. 2018), and contribute to PGPR root colonization (Santaella et al. 2008). For example, Meneses et al. (2017) reported that Gluconacetobacter diazotrophicus EPS protects bacterial cells against oxidative stress in vitro and during rice plant colonization. Our recent study also demonstrated that strain KLBMP 5180 secretes EPS (data not shown). Thus, in the present study, this positive effect may be correlated with the ability of G. halophytocola KLBMP 5180 to exhibit multiple PGP traits, which we speculate to be mainly due to EPS production.
The G. halophytocola KLBMP 5180 genome also has a series of genes involved in salinity resistance, including Na+/H+ antiporters, K+ transporter, and glycine-betaine synthesis and transporter encoding genes. These transporters act as regulating the outflow and uptake of protons and Na+/ K+, maintaining intracellular ion balance, and therefore support the growth of bacteria under salt stress. These genes were also detected in recently described halotolerant PGPR strains (Liu et al. 2016; Wang et al. 2017). Moreover, some genes resistant to heavy metals were also detected. The presence of these genes reveals the diverse environmental adaptation capacity and mechanism of strain KLBMP 5180 and indicates that the strain has the potential in bioremediation of sites that have heavy metal contamination. Interestingly, some genes that encode the biodegradation process, such as phenylacetic acid, 4-hydroxyphenylacetate, and phenol degradation-related genes, were also present in the genome, indicating its biodegradation potential of organic pollutants. Therefore, combined with the PGP ability, this strain could be potentially used for phytoremediation and help sustainable development in agriculture as well as environmental protection. In summary, the genomic information provides useful clues to explain the plant growth-promoting ability and environmental adaptability of the actinobacterium, and reveals some potential new functions, which is worthy of further exploration and research.
Conclusions
In conclusion, the PGP effect of a natural halotolerant actinobacterium G. halophytocola KLBMP 5180 was explored in tomato seedlings under the high salt stress condition. Current studies have proven that this strain can also successfully colonize in the rhizosphere of non-host tomato plants and significantly enhance its growth under salinity stress. Therefore, this PGP strain has the potential for subsequent development as a new type of biofertilizer. Furthermore, we revealed that the strain could improve the salt tolerance of tomato seedlings by regulating plant osmoprotectants and antioxidant enzymes accumulation, and ion balance and ultimately promote its growth under salt stress. Genome analysis also revealed the molecular mechanism of the strain’s PGP and salt-alkaline tolerance capacity. In addition, unsolved problems remain, such as the potential PGP capacity evaluation of the actinobacterium in the field condition, its phytoremediation of heavy metals and biodegradation of environmental organic pollutants, as well as whether the exopolysaccharide secreted by this strain is helpful to its rhizosphere colonization, recruitment, and salt stress adaptation is worthy of further study and experimental verification.
References
Afzal M, Khan QM, Sessitsch A (2014) Endophytic bacteria: prospects and applications for the phytoremediation of organic pollutants. Chemosphere 117:232–242
Akram MS, Shahid M, Tariq M, Azeem M, Javed MT, Saleem S, Riaz S (2016) Deciphering Staphylococcus sciuri SAT-17 mediated anti-oxidative defense mechanisms and growth modulations in salt stressed maize (Zea mays L.). Front Microbiol 7:867
Ali S, Charles TC, Glick BR (2014) Amelioration of high salinity stress damage by plant growth-promoting endophytes that contain ACC deaminase. Plant Physiol Biochem 80:160–167
Banik A, Pandya P, Patel B, Rathod C, Dangar M (2018) Characterization of halotolerant, pigmented, plant growth promoting bacteria of groundnut rhizosphere and its in-vitro evaluation of plant-microbe protocooperation to withstand salinity and metal stress. Sci Total Environ 630:231–242
Barnawal D, Bharti N, Pandey SS, Pandey A, Chanotiya CS, Kalra A (2017) Plant growth-promoting rhizobacteria enhance wheat salt and drought stress tolerance by altering endogenous phytohormone levels and TaCTR1/TaDREB2 expression. Physiol Plant 161:502–514
Beauchamp CO, Fridovich I (1971) Superoxide dismutase: improved assays and an assay applicable to acrylamide gels. Anal Biochem 44:276–287
Berg G, Rybakova D, Grube M, Köberl M (2016) The plant microbiome explored: implications for experimental botany. J Exp Bot 67:995–1002
Blin K, Wolf T, Chevrette MG, Lu X, Schwalen CJ, Kautsar SA et al (2017) antiSMASH 4.0-improvements in chemistry prediction and gene cluster boundary identification. Nucleic Acids Res 45(W1):W36–W41
Busse HJ (2016) Review of the taxonomy of the genus Arthrobacter, emendation of the genus Arthrobacter sensu lato, proposal to reclassify selected species of the genus Arthrobacter in the novel genera Glutamicibacter gen. nov., Paeniglutamicibacter gen. nov., Pseudoglutamicibacter gen. nov., Paenarthrobacter gen. nov. and Pseudarthrobacter gen. nov., and emended description of Arthrobacter roseus. Int J Syst Evol Microbiol 66:9–37
Caarls L, Pieterse CM, Van Wees SC (2015) How salicylic acid takes transcriptional control over jasmonic acid signaling. Front Plant Sci 6:170
Chen L, Liu Y, Wu G, Veronican Njeri K, Shen Q, Zhang N, Zhang R (2016) Induced maize salt tolerance by rhizosphere inoculation of Bacillus amyloliquefaciens SQR9. Physiol Plant 158(1):34–44
Chen L, Liu Y, Wu G, Zhang N, Shen QR, Zhang R (2017) Beneficial rhizobacterium Bacillus amyloliquefaciens SQR9 induces plant salt tolerance through spermidine production. Mol Plant-Microbe Interact 30(5):423–432
Cuartero J, Bolarín MC, Asíns MJ, Moreno V (2006) Increasing salt tolerance in the tomato. J Exp Bot 57:1045–1058
Cycoń M, Mrozik A, Piotrowska-Seget Z (2017) Bioaugmentation as a strategy for the remediation of pesticide-polluted soil: a review. Chemosphere 172:52–71
Damodharan K, Palaniyandi SA, Le B, Suh JW, Yang SH (2018) Streptomyces sp. strain SK68, isolated from peanut rhizosphere, promotes growth and alleviates salt stress in tomato (Solanum lycopersicum cv. Micro-Tom). J Microbiol 56(10):753–759
Delcher AL, Bratke KA, Powers EC, Salzberg SL (2007) Identifying bacterial genes and endosymbiont DNA with glimmer. Bioinformatics 23:673–679
Dubois M, Gilles KA, Hamilton JK, Rebers PA, Smith F (1956) Calorimetric method for determination of sugars and related substances. Anal Chem 28:350–356
El-Esawi MA, Alaraidh IA, Alsahli AA, Alamri SA, Ali HM, Alayafi AA (2018) Bacillus firmus (SW5) augments salt tolerance in soybean (Glycine max L.) by modulating root system architecture, antioxidant defense systems and stress-responsive genes expression. Plant Physiol Biochem 132:375–384
Fan P, Chen D, He Y, Zhou Q, Tian Y, Gao L (2016) Alleviating salt stress in tomato seedlings using Arthrobacter and Bacillus megaterium isolated from the rhizosphere of wild plants grown on saline-alkaline lands. Int J Phytoremediation 18:1113–1121
Feng WW, Wang TT, Bai JL, Ding P, Xing K, Jiang JH, Peng X, Qin S (2017) Glutamicibacter halophytocola sp. nov., an endophytic actinomycete isolated from the roots of a coastal halophyte, Limonium sinense. Int J Syst Evol Microbiol 67:1120–1125
Glick BR (2014) Bacteria with ACC deaminase can promote plant growth and help to feed the world. Microbiol Res 169:30–39
Gong Y, Bai JL, Yang HT, Zhang WD, Xiong YW, Ding P, Qin S (2018) Phylogenetic diversity and investigation of plant growth-promoting traits of actinobacteria in coastal salt marsh plant rhizospheres from Jiangsu, China. Syst Appl Microbiol 41(5):516–527
Heath RL, Packer L (1968) Photoperoxidation in isolated chloroplasts. Kinetics and stoichiometry of fatty acid peroxidation. Arch Biochem Biophys 125:189–198
Jamil A, Riaz S, Ashraf M, Foolad MR (2011) Gene expression profiling of plants under salt stress. Crit Rev Plant Sci 30:435–458
Kar M, Mishra D (1976) Catalase, peroxidase, and polyphenol oxidase activities during rice leaf senescence. Plant Physiol 57:315–319
Kim K, Jang YJ, Lee SM, Oh BT, Chae JC, Lee KJ (2014) Alleviation of salt stress by Enterobacter sp. EJ01 in tomato and Arabidopsis is accompanied by up-regulation of conserved salinity responsive factors in plants. Mol Cell 37:109–117
Krzywinski M, Schein J, Birol I, Connors J, Gascoyne R, Horsman D, Jones SJ, Marra MA (2009) Circos: an information aesthetic for comparative genomics. Genome Res 19:1639–1645
Li R, Zhu H, Ruan J, Qian W, Fang X, Shi Z, Li Y, Li S, Shan G, Kristiansen K, Li S, Yang H, Wang J, Wang J (2010) De novo assembly of human genomes with massively parallel short read sequencing. Genome Res 20:265–272
Li T, Yang X, Yu Y, Si X, Zhai X, Zhang H, Dong W, Gao C, Xu C (2018) Domestication of wild tomato is accelerated by genome editing. Nat Biotechnol 36:1160–1163
Liu W, Wang Q, Hou J, Tu C, Luo Y, Christie P (2016) Whole genome analysis of halotolerant and alkalotolerant plant growth-promoting rhizobacterium Klebsiella sp. D5A. Sci Rep 6:26710
Liu X, Luo Y, Li Z, Wang J, Wei G (2017) Role of exopolysaccharide in salt stress resistance and cell motility of Mesorhizobium alhagi CCNWXJ12-2T. Appl Microbiol Biotechnol 101(7):2967–2978
Lu X, Liu SF, Yue L, Zhao X, Zhang YB, Xie ZK, Wang RY (2018) Epsc involved in the encoding of exopolysaccharides produced by Bacillus amyloliquefaciens FZB42 act to boost the drought tolerance of Arabidopsis thaliana. Int J Mol Sci 19(12):E3795
Ma Y, Rajkumar M, Zhang C, Freitas H (2016) Beneficial role of bacterial endophytes in heavy metal phytoremediation. J Environ Manag 174:14–25
Meneses C, Gonçalves T, Alquéres S, Rouws L, Serrato R, Vidal M, Baldani JI (2017) Gluconacetobacter diazotrophicus exopolysaccharide protects bacterial cells against oxidative stress in vitro and during rice plant colonization. Plant Soil 416:133–147
Mickelbart MV, Hasegawa PM, Bailey-Serres J (2015) Genetic mechanisms of abiotic stress tolerance that translate to crop yield stability. Nat Rev Genet 16:237–251
Munns R, Tester M (2008) Mechanisms of salinity tolerance. Annu Rev Plant Biol 59:651–681
Myers EW, Sutton GG, Delcher AL et al (2000) A whole-genome assembly of Drosophila. Science 287:2196–2204
Niu SQ, Li HR, Paré PW, Aziz M, Wang SM, Shi H, Li J, Han QQ, Guo SQ, Li J, Guo Q, Ma Q, Zhang JL (2016) Induced growth promotion and higher salt tolerance in the halophyte grass Puccinellia tenuiflora by beneficial rhizobacteria. Plant Soil 407(1):217–230
Palaniyandi SA, Damodharan K, Yang SH, Suh JW (2014) Streptomyces sp. strain PGPA 39 alleviates salt stress and promotes growth of “Micro Tom” tomato plants. J Appl Microbiol 117:766–773
Pereira SIA, Moreira H, Argyras K, Castro PML, Marques APGC (2016) Promotion of sunflower growth under saline water irrigation by the inoculation of beneficial microorganisms. Appl Soil Ecol 105:36–47
Płociniczak T, Chodór M, Pacwa-Płociniczak M, Piotrowska-Seget Z (2018) Metal-tolerant endophytic bacteria associated with Silene vulgaris support the Cd and Zn phytoextraction in non-host plants. Chemosphere 219:250–260
Pruitt KD, Tatusova T, Brown GR, Maglott DR (2012) NCBI reference sequences (RefSeq): current status, new features and genome annotation policy. Nucleic Acids Res 40:D130–D135
Qin S, Xing K, Jiang JH, Xu LH, Li WJ (2011). Biodiversity, bioactive natural products and biotechnological potential of plant-associated endophytic actinobacteria. Appl Microbiol Biotechnol 89 (3): 457–473
Qin S, Zhang YJ, Yuan B, Xu PY, Xing K, Wang J, Jiang JH (2014) Isolation of ACC deaminase-producing habitat-adapted symbiotic bacteria associated with halophyte Limonium sinense (Girard) Kuntze and evaluating their plant growth-promoting activity under salt stress. Plant Soil 374:753–766
Qin S, Miao Q, Feng WW, Wang Y, Zhu X, Xing K, Jiang JH (2015) Biodiversity and plant growth promoting traits of culturable endophytic actinobacteria associated with Jatropha curcas L. growing in Panxi dry-hot valley soil. Appl Soil Ecol 93:47–55
Qin S, Li WJ, Dastager SG, Hozzein WN (2016) Editorial: actinobacteria in special and extreme habitats: diversity, function roles, and environmental adaptations. Front Microbiol 7:1415
Qin S, Feng WW, Wang TT, Ding P, Xing K, Jiang JH (2017) Plant growth-promoting effect and genomic analysis of the beneficial endophyte Streptomyces sp. KLBMP 5084 isolated from halophyte Limonium sinense. Plant Soil 416:117–132
Qin S, Feng WW, Zhang YJ, Wang TT, Xiong YW, Xing K (2018) Diversity of bacterial microbiota of coastal halophyte Limonium sinense and amelioration of salinity stress damage by symbiotic plant growth-promoting actinobacterium Glutamicibacter halophytocola KLBMP 5180. Appl Environ Microbiol 84(19):e01533–e01518
Ramadoss D, Lakkineni VK, Bose P, Ali S, Annapurna K (2013) Mitigation of salt stress in wheat seedlings by halotolerant bacteria isolated from saline habitats. Springerplus 2:1–7
Rozema J, Flowers T (2008) Ecology: crops for a salinized world. Science 322:1478–1480
Santaella C, Schue M, Berge O, Heulin T, Achouak W (2008) The exopolysaccharide of Rhizobium sp. YAS34 is not necessary for biofilm formation on Arabidopsis thaliana and Brassica napus roots but contributes to root colonization. Environ Microbiol 10(8):2150–2163
Sarkar A, Ghosh PK, Pramanik K, Mitra S, Soren T, Pandey S, Mondal MH, Maiti TK (2018) A halotolerant Enterobacter sp. displaying ACC deaminase activity promotes rice seedling growth under salt stress. Res Microbiol 169:20–32
Sharma S, Kulkarni J, Jha B (2016) Halotolerant rhizobacteria promote growth and enhance salinity tolerance in peanut. Front Microbiol 7:1600
Sheibani-Tezerji R, Rattei T, Sessitsch A, Trognitz F, Mitter B (2015) Transcriptome profiling of the endophyte Burkholderia phytofirmans PsJN indicates sensing of the plant environment and drought stress. MBio 6(5):e00621–e00615
Shilpi M, Narendra T (2005) Cold, salinity and drought stresses: an overview. Arch Biochem Biophys 444:139–158
Shirling EB, Gottlieb D (1966) Methods for characterization of Streptomyces species. Int J Syst Bacteriol 16:313–340
Singh RP, Jha PN (2017) The PGPR Stenotrophomonas maltophilia SBP-9 augments resistance against biotic and abiotic stress in wheat plants. Front Microbiol 8:1945
Turhan A, Seniz V (2012) Salt tolerance during vegetative growth in cross of tomato and effect of cytoplasm in response to salt tolerance. Bulg J Agric Sci 18:207–218
Van Oosten MJ, Di Stasio E, Cirillo V, Silletti S, Ventorino V, Pepe O, Raimondi G, Maggio A (2018) Root inoculation with Azotobacter chroococcum 76A enhances tomato plants adaptation to salt stress under low N conditions. BMC Plant Biol 18(1):205
Viegas CA, Silva VP, Varela VM, Correia V, Ribeiro R, Moreira-Santos M (2019) Evaluating formulation and storage of Arthrobacter aurescens strain TC1 as a bioremediation tool for terbuthylazine contaminated soils: efficacy on abatement of aquatic ecotoxicity. Sci Total Environ 668:714–722
Wang TT, Ding P, Chen P, Xing K, Bai JL, Wan W, Jiang JH, Qin S (2017) Complete genome sequence of endophyte Bacillus flexus KLBMP 4941 reveals its plant growth promotion mechanism and genetic basis for salt tolerance. J Biotechnol 260:38–41
Wani ZA, Ashraf N, Mohiuddin T, Riyaz-Ul-Hassan S (2015) Plant-endophyte symbiosis, an ecological perspective. Appl Microbiol Biotechnol 99:2955–2965
Wei D, Zhang W, Wang C, Meng Q, Li G, Chen THH, Yang X (2017) Genetic engineering of the biosynthesis of glycinebetaine leads to alleviate salt-induced potassium efflux and enhances salt tolerance in tomato plants. Plant Sci 257:74–83
Win KT, Tanaka F, Okazaki K, Ohwaki Y (2018) The ACC deaminase expressing endophyte Pseudomonas spp. enhances NaCl stress tolerance by reducing stress-related ethylene producing, resulting in improved growth, photosynthetic performance, and ionic balance in tomato plants. Plant Physiol Biochem 127:599–607
Yang H, Hu J, Long X, Liu Z, Rengel Z (2016) Salinity altered root distribution and increased diversity of bacterial communities in the rhizosphere soil of Jerusalem artichoke. Sci Rep 6:20687
Zhang JL, Aziz M, Qiao Y, Han QQ, Li J, Wang YQ, Shen X, Wang SM, Paré PW (2014) Soil microbe Bacillus subtilis (GB03) induces biomass accumulation and salt tolerance with lower sodium accumulation in wheat. Crop Pasture Sci 65:423–427
Zhang L, Zhong J, Liu H, Xin K, Chen C, Li Q, Wei Y, Wang Y, Chen F, Shen X (2017) Complete genome sequence of the drought resistance-promoting endophyte Klebsiella sp. LTGPAF-6F. J Biotechnol 246:36–39
Zhang Y, Li T, Liu Y, Li X, Zhang C, Feng Z, Peng X, Li Z, Qin S, Xing K (2019) Volatile organic compounds produced by Pseudomonas chlororaphis subsp. aureofaciens SPS-41 as biological fumigants to control Ceratocystis fimbriata in postharvest sweet potatoes. J Agric Food Chem 67(13):3702–3710
Acknowledgements
This work was supported by the National Natural Science Foundation of China (31370062), Promoting Science and Technology Innovation Project of Xuzhou City (KC18142), Qing Lan Project of Jiangsu Province (2019), and by the Postgraduate Research & Practice Innovation Program of Jiangsu Province (KYCX18_2139).
Author information
Authors and Affiliations
Corresponding author
Ethics declarations
Conflict of interest
None.
Additional information
Responsible Editor: Stéphane Compant.
Publisher’s note
Springer Nature remains neutral with regard to jurisdictional claims in published maps and institutional affiliations.
Rights and permissions
About this article
Cite this article
Xiong, YW., Gong, Y., Li, XW. et al. Enhancement of growth and salt tolerance of tomato seedlings by a natural halotolerant actinobacterium Glutamicibacter halophytocola KLBMP 5180 isolated from a coastal halophyte. Plant Soil 445, 307–322 (2019). https://doi.org/10.1007/s11104-019-04310-8
Received:
Accepted:
Published:
Issue Date:
DOI: https://doi.org/10.1007/s11104-019-04310-8